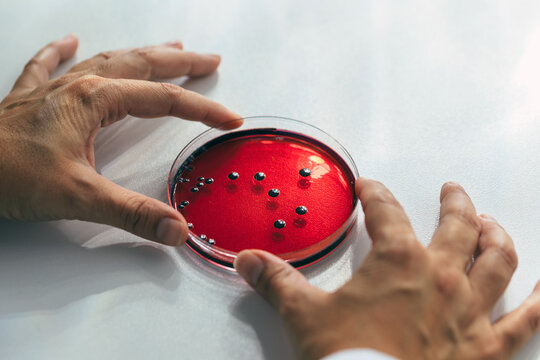
Woman examining petri dishes in the lab

Essai gratuit : obtenez 10 images Stock, plus des outils d’édition par IA.
Essai gratuit : obtenez 10 images Stock, plus des outils d’édition par IA.
Nouveaux filtres ajoutés
Trier par
446 résultats pour ..hormone dans Premium
Sélectionner votre zone géographique
La sélection d’une zone géographique peut modifier la langue et le contenu promotionnel affiché sur le site web Adobe Stock.
Amérique du Nord
Amérique du Sud
- Venezuela
- Algeria - English
- Armenia - English
- Azerbaijan - English
- Bahrain - English
- Belgium - English
- Belgique - Français
- België - Nederlands
- Česká republika
- Croatia - English
- Cyprus - English
- Danmark
- Georgia - English
- Deutschland
- Eesti
- Egypt - English
- España
- France
- Greece - English
- Iceland - English
- Ireland
Europe, Moyen-Orient et Afrique
- Israel - English
- Italia
- Jordan - English
- Казахстан
- Kenya - English
- Kuwait - English
- Киргизия
- Latvija
- Lebanon - English
- Lietuva
- Luxembourg - Deutsch
- Luxembourg - English
- Luxembourg - Français
- Mauritius - English
- Moldova - English
- Hungary - English
- Malta - English
- Morocco - English
- Nederland
- Nigeria
- Norge
- Oman - English